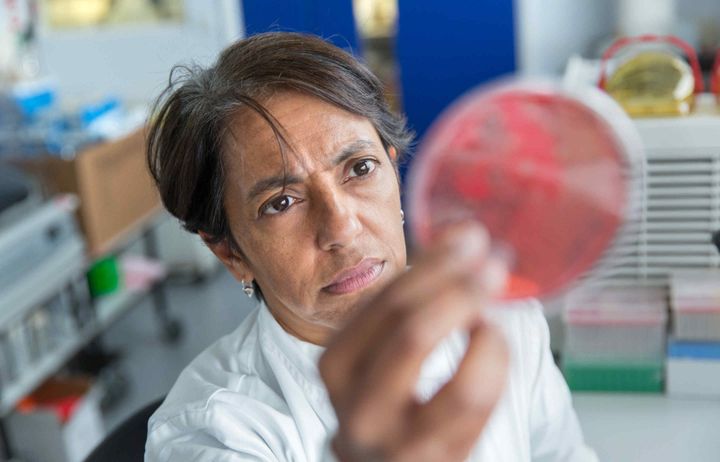

Research

The Department of Infectious Disease, with over 70 principal investigators, is one of the largest centres of infectious disease research in Europe. The Department operates across sites at Hammersmith Hospital, St Mary's Hospital, South Kensington Campus, Chelsea & Westminster Hospital and Northwick Park Hospital.
Research in the Department ranges from the fundamental biology of infectious diseases to the development and application of new approaches to treatment. There are major research programmes in human immunology and retrovirology, oncogenic human viruses, molecular microbiology, tuberculosis and vaccine development.